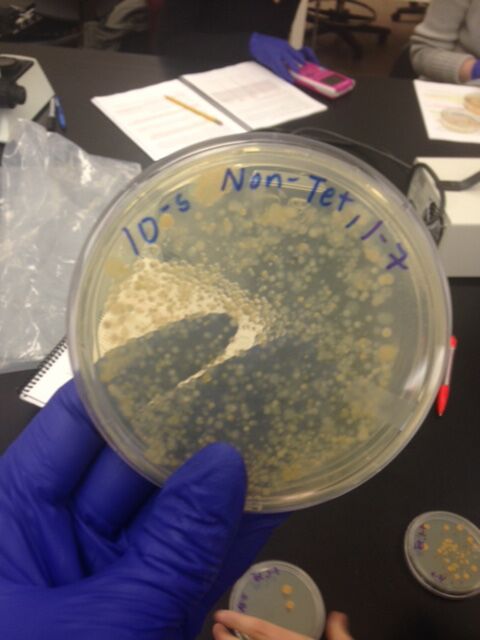

User:Anne P Li/Notebook/Biology 210 at AU
Zebrafish Embryos and Effect of Exposure to Nicotine on Embryogenesis
Purpose: The purpose of this experiment is to study the effect of nicotine on embryonic development in zebra fish. We hypothesize that nicotine exposure will have adverse affects on embryologists. This study will be relevant for comparable studies in the future on human embryos. If a zebra fish embryo is exposed to nicotine, then their developmental pathway and cognitive growth will be negatively affected, with no exposure to nicotine a zebra fish will have a higher success rate in full development both physically and cognitively.
Methods and Materials: Using petri dishes, a microscope, a pipette, 20mL of water, and a nicotine solution we conducted a control and variable experiment. First, a control and a variable petri dish were set up containing 20 live zebra fish translucent embryos in each dish. One petri dish consisted of 20mL water and a nicotine solution, and the other only had 20mL of water. For two weeks we observed the zebra fish for their motility, size, shape, and ultimately, whether or not they were alive. On the fourth day, we remove 10 ml of solution from the control and variable solutions and added 25 ml of water into the control and 25 ml of nicotine solution to variable petri dish containing zebra fish. We also made sure to remove any dead fish and preserve zebra fish in paraformaldehyde, to observe them for their current state later on. After a week, we added paramecium to each of the dishes to feed the zebra fish. We also removed 5mL of water and added 10mL of water to both dishes to keep the solution fresh. On the last day, we made final observations and measurements of our zebra fish.
Data and Observations: The first check in date, the fourth day after setting up the experiment, we observed that 20 fish survived in the control solution and in nicotine solution three zebra fish had died, leaving a remainder of 17 zebra fish. A week later, the number of live fish in the control was 17, losing 3 fish from the last dated observations, and the nicotine solution contained 2 live fish, losing 15 fish. On the last day, after two weeks, there were no surviving fish in either of the dishes. Throughout our experiment we observed that fish in nicotine solutions, compared with the control, were smaller, less motile, undergoing organ failure, and were observing a blackish/grey pigmentation. The zebra fish in the control, though they all died, experienced healthier lives, physically and developmentally, than those in the nicotine solution.
Conclusion: We conclude that our experiment supports our hypothesis, though further research needs to be done. Techincal difficulties were experienced. Some of the solution fell out of both of the petri dishes and the control may have been contaminated with some nicotine through out the experience.
AL
PCR for 16s Sequencing, March 5, 2015
Purpose: The purpose of the experiment was to characterize bacteria from the Hay Infusion cultures using 1 bacteria colony from the nutrient agar plates and 1 bacteria colony from the tetracycline plates. The DNA from the bacteria will be isolated and run through a PCR machine in order to amplify the 16s rRNA gene that is specific to each bacteria in order to characterize what bacteria's we have been analyzing all along. Understanding what bacteria exists in our transect is an important method to understanding how organisms coexist together and what the role of specific bacteria are in sustaining the health of the niche. Our hypothesis is that DNA sequencing will shed light into what type of bacteria we are specifically dealing with, and if the DNA sequencing matches up in certain chacterisitis as ours (such as shape, size, and gram negative), then we have conducted a successful experiment.
Materials and Methods: The experiment was a continuation of the January 29th lab. To initiate the PCR experiment and DNA sequencing, bacteria from the two plates was transferred into a tube in 100 microliters of water. Then the tubes were incubated for 10 minutes in a heating block of 100 degrees celcius. Then the samples were centrifuged for 5 minutes. While the centrifugation process was taking place, 20 microliters of a primer water mixture was placed in the PCR tube. This tube was mixed until the PCR bead, found at the bottom of the tube, dissolved. Finally 5 microliters from the centrifuged samples were placed in the PCR tubes. The following week, the products from the PCR reaction were placed into agarose gel and observed on a DNA ladder and analyzed. These two bacteria were then sent back for DNA sequencing. The results from the DNA sequencing were confirmed and a code for each bacteria was encrypted. Then, a 'blast' website was utilized to encrypt the codes and give the specific DNA sequence, which helps to confirm what type of specific bacteria each bacteria were.
Data and observations: Tube - MB21
Conclusion: Our data from the DNA sequencing resulted in a bacteria, pseudoomona, that is gram-negative which matches up with the characterization of our bacteria colony. However, the size and shape do not match up with what we originally presumed about our bacteria when observing under a microscope. The data is inconclusive as many errors were made during the conduction of the lab.
Lab 5, Part 2, Vertebrates and Niches
Purpose: The purpose of this lab was to conclude the time we have spent analyzing our designated transect. We were to observe animals that occupy our transect throughout the day and understand their role in keeping the ecosystem sustainable. The protists, fungi, plants, invertebrates, and vertebrates examined throughout the course of 6 weeks all play a very influential part in creating an ecosystem that can be beneficial to surrounding organisms and the cycle of the living things inhabiting the earth.
Materials and Methods: Binoculars may be helpful, a device for note taking and a nice day are important qualities for this part of the lab. Observe the transect for a significant amount of time in order to understand the range of animals that may inhabit the transect. Take special note of the animals' classifications, their phylum and any biotic and abiotic characteristic that benefit the species.
Data and Observations: After observing the transect on a sunny day for a half hour I was able to view 4 animals that inhabited the transect for a period of time. These animals were squirrels from the Sciurus Carolinesis phylum, birds from Chordata phylum, from Chordata phylum, a dog from the Chordate phylum, and a chipmunk, from the Chordata phylum, class: Mammalia. There were two different squirrels: a grey squirrel and a black squirrel, and the birds ranged from a small brown bird to a larger, darker bird. The animals interacted with the transect with some beneficial features-- the birds used the sticks from the transect to create a nest and could soil insects, the squirrels similarly used the transect for food and protection, the dog could smell what previous animals may have been there and marked the territory as well. The tall plants acted as protection for the small rodents and bird. The food web would be dog and bald eagle on top, black squirrel and grey squirrel next, then the invertabrates, and the plants would be at the bottom of the food chain.
Conclusions: The conclusion of the Transect Lab is that there are so many organisms that help the survival of an ecosystem. The diverstity and uniqueness of the plants, animals, fungi, and protists play a unique role in the success of the transect's ecosystem and it is important to realize these differences. From understanding these differences, we can observe what functions are important for an ecosystem's survival, and what are harmful. Also, we were able to analyze what conditions were optimal for the organisms success.
AL
Lab 5, Part 1, invertebrates
Purpose: The purpose of this lab was to understand the invertebrates that are living within our transect and understand their specific characteristics that help in their survival. Their inhabitance has important affects on the survival of the transect. Soil animals help in breaking down and recycling decomposing plant and animal material in order to maintain the ecosystem's health.
Therefore, the hypothesis is that by observing the soil invertebrates from our transect, the diversity and importance of invertebrates would be appreciated. The lab also included observing acoelomates, pseudocoelomates, and coelomates in order to understand the extent of diversity of invertebrates.
Materials and Methods: A Berlese Funnel with the transect components, after sitting for 1 week, is needed, multiple petri dishes, and a microscope will also be utilized. A chart in order to identify the insects is needed too. First, obtain a sample of soil from the Berlese Funnel and pour the top 10 mLs of liquid and organisms into a petri dish and the remaining liquid into a second dish to examine what life exists where (close to the light or far away). Poke the sample around in order to try to create movement of the organisms and observe under a microscope.
Data and Observations: The organisms observed in the microscope were identified as arachnida, diplopoda, chilopoda, insect or crustacea, all arthropods. Classified in differences of number of body parts, body segments, and appendages.
Conclusions: All of the soil insects help in the process of breaking down and recycling decomposing plant and animal matter. The structures lack intensive support, but have diverse structures for movement and are important decomposers. The insects were found in different parts of the soil sample, some right in the soil, some more in the liquid, and some differ in their location of being either at the top of the funnel o found in the bottom.
AL
Lab 4, Plantae and Fungi
Purpose: The essnce of this lab was to observe fungi and plants in our transect and understand their vital roles in maintains the health of the ecosystem. Each plant and fungi play an essential role to all living things on Earth. The main purpose of the lab was to identify unique characteristics of each plant. Five plants were collected from the transect and evaluated based on vascularization, leaves and special characteristics, and reproductive elements. The hypothesis of this lab is that each plant and fungi play a specific role in the health of an ecosystem and its survival, and therefore each compenent that makes up the plant and fungi will be unique and serve specific and vital functions. We compared different fungi and plantae with already made slides to deepen our understanding of both plants and fungi while we observed the 5 plants from our transect.
Materials and Methods: Our lab needed a microscope, 5 respective plant or fungi samples from our transect and a zip lock bag to contain the elements, accessories to prepare a Berlese funnel (ethanol, water, tape, and screening material, foil, and a light), a funnel, a ruler, and microscope slides. First, collect the plant samples at your transect, next evaluate them and their diverese vascularization system, reproductive characteristics, size, shape, color and their leaves and possible spores. Note any unique features. Next, attempt to identify what specfically these plants/fungi are. Then, create a Berlese Funnel in order to collect any invertebrates inhabiting your transect.
Data and Observations:
Data and observations of the 5 plant samples is discussed in the table (1.0), followed by pictures coordinating with the sample number. The plants may have been changed due to lack of sunlight and the affects of winter. We did not collect any fungi.
Data and Conclusions: The plants are all diverse and are essential to today's ecosystem. The plants also have important microorganisms living all around them and hopefully have a symbiotic relationship. The hypothesis that plants are diverse was shown in that each plant had a unique vascurilization system, they had a unique reproductive system, size and shape varied, and so did the leaf structures.
AL
Lab 3, Microbiology and Identifying Bacteria with DNA sequences, February 4
Purpose: The purpose of this lab is to observe the affects of a antibiotic, tetracycline, on the bacteria from the Hay Infusion. The Hay Infusion had gotten smellier and was more settled. There are more bacteria growing while plant matter is breaking down, resulting in a more settled ecosystem. Once we place the bacteria from the Hay Infusion on an agar plate with tetracyclin, it is predicted that The inhibition factor of tetracycline will make it so that a limited amount of bacteria will be growing on the agar plates with the tetracycline. Another purpose of the lab was to understand PCR and to perform DNA sequencing.
Materials and Methods: For the dilution -4 test tubes, micropippeter, nutrient agar and nutreitn agar plus tetracycline plates, a sharpie, the Hay Infusion To analyze the agar plates- sterile loop, bunsen burner, microscope, slides, cyrstal violet, staining tray, gram's iodine, 95% alchohol, water, kemwipe For PCR: Centrifuge, colony of bacteria from hay infusion, PCR bead and tube, PCR machine
From the previous lab, a serial dilution should have been made for the agar plates. After a week, one can observe the agar plates.Make a gram stained slide for each of the agar plates and observe under a microscope to see if the bacteria is gram positive or negative. Record data. Then, isolate your bacteria and set up a PCR for 16s sequencing using a centrifuge and PCR tube.
Data and Observations: The non-tetracycline plates contained more colonies than the tetracycline plates. The non-tetracycline plates were more colorful. where the tetracycline plates contained dark orange colonies. The antibiotic agar plates observed fewer colonies of bacteria than those plates without the tetracycline.

Dilution Agar Type Colonies Counted Conversion Factor
10^-3 Nutrient Lawn X10^3 10^-5 Nutrient Lawn X10^5 10^-7 Nutrient 90 X10^7 10^-9 Nutrient 53 X10^9 10^-3 Nutrient + tet 75 X10^3 10^-5 Nutrient + tet 2 X10^5 10^-7 Nutrient + tet 40 X10^7 10^-9 Nutrient + tet 11 X10^9
'Table 2
Colony Label Plate Type Colony Description Cell Description Gram+/- 10^-5 Non Tet lawn motile - 10^-7 Tet many colonies no motility - 10^-9 Non Tet lawn/yellow + 10^5 Tet circular, orange, smooth +
Conclusion: The hypothesis that the agar plate with the antibiotic tetracycline would observe less, or no, bacteria, compared to the plates without the antibiotic resistance, was accurate. With the presence of tetracycline the total number of bacteria is decreased compared to the plates without tetracycline.
AL
Lab 2, Identifying Algae and Protists, January 29
Purpose: This week's lab's purpose is to utilize a dichotomous key to identify unicellular eukarya living in the Hay Infusion. Protists and algae are two organisms most identified in the Hay Infusion. Using a sample collected from the bottom of the Hay Infusion culture, near the soil, and one taken from the middle of the culture, we observed differences in what protists and algae were living where and what organisms do best in which environment (the soil or on the surface of the Hay Infusion).
Materials and Methods: Dichotomous key, microscope, Hay Infusion
Make a wet mount, from the surface and bottom of the Hay Infusion after it has sat for 1 week and observe with a microscope. Use a dichotomous key to identify the microorganism living in the ecosystem. Make sure to note which slide was from the top and which came from the bottom of the culture. Observe the characteristics of the eukaryotes and note the motility, size and shape and attempt to identify what organisms they are exactly.
Data and Observations: The Hay Culture had a potent, sour smell. The amount of water left in the Hay Infusion had decreased since it was first created. The bottom of the culture had settled, there were four protists (~50um) observed and they were motile and oval shaped. Unicellular Algae was identified and they were small and round (12 um, 13 um, 15 um, 20 um), we identified the algae as Chlamydomonas based on the dichotomous key.
The organisms found in the Hay Culture were motile and there were at least 3 or 4 at any given time, from the surface and from the dirt. We identified Chlamydomonas algae, taken from the surface of the Hay Infusion, and a protist at the bottom of the Hay Infusion.


Conclusions: We believe the algae was at the surface because it needs photosynthesis to survive and therefore needs the sunlight. The protozoa identified, Colpidium, were living at the bottom of the culture to absorb nutrients needed in order to survive. I hypothesize that if the Hay Infusion Culture grew for another few months, more microorganisms would reproduce and thrive in the culture as it has soil, plants and oygen and light for the microorganisms to survive. Eventually, the carrying capacity would overpopulate and the Hay Infusion should go back into its natural place to let the organisms survive.
AL
Lab 1, Biological Life at AU, January 25
Purpose: Observe environmental factors in a 20x20 transect (transect #1), while observing the abiotic and biotic characteristics in the ecosystem, as well as observing other factors of its terrain. The artifacts that we collect from the transect will be used for a Hay Infusion to observe what time of organisms were coexisting within elements of the transect. The location of the Hay Infusion was in front of KoGod and on the left of Massachusetts Ave in Washington, D.C. The transect was not huge but it had many bushes and a lot of soil.
Materials & Methods: Microscope, Hay Infusion Jar materials, 50 mL conical tube for gathering elements of transect, Agar plates and tetracycline plates, Dichotomous key, test tubes, ethanol and a Bunsen Burner for sterilization, dried milk, and micropipette will be utilized in this lab.
Collect the necessary materials from your transect and then go to the lab and create a wet mount slide from your transect in order to view the organisms living in the transect under a microscope. Next, a Hay Infusion is to be made from the transect using 0.1 gm dried milk.
Data and Observations: The transect had many different characteristics that led to the making of a diverse Hay Culture. There were abiotic and biotic features included in the transect area.
Conclusions: I conclude that the Hay Infusion will culture a similar environment as the one outside and that many organisms are eisting in the Hay Infusion culture. Next week the Hay Infusion will further be monitored. The transect itself will change from now (the winter) into the spring, there will be more flowers and more organisms will be able to exist in the transect come April and May.
AL: